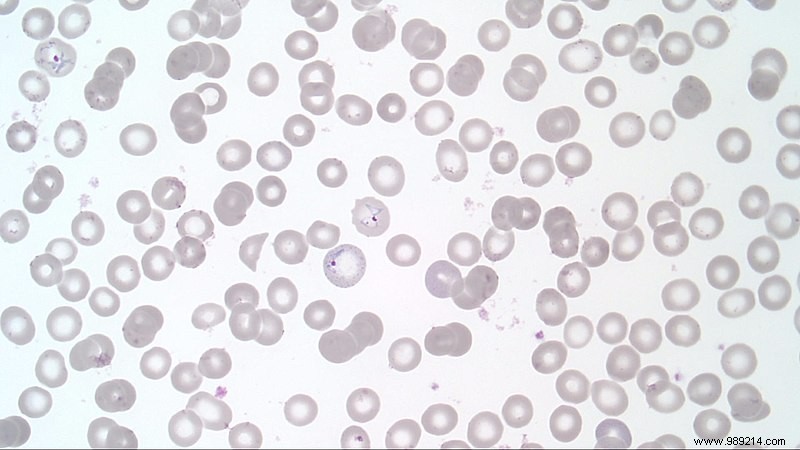
Mutant Malaria Parasite in Ethiopia Evades Standard Tests, Threatening Treatment Efforts

In Ethiopia, the Plasmodium falciparum parasite causing malaria has mutated, evading proteins targeted by routine screening tests. These tests are essential for vulnerable populations, making this a critical concern.
The World Health Organization (WHO) recently endorsed widespread use of the first malaria vaccine in high-risk areas like sub-Saharan Africa—a timely step that could save countless lives. Yet, a study in Nature Microbiology (September 27, 2021) reveals that Plasmodium falciparum—transmitted by Anopheles mosquitoes—is mutating in ways that undermine detection.
These rapid diagnostic tests, deployed for 15 years, have been key to controlling malaria, which claims around 400,000 lives annually worldwide—70% children under five. This mutation now jeopardizes those gains.
Jane Cunningham, co-author and WHO Global Malaria Programme researcher, observed anomalies as early as 2016: symptomatic children testing negative despite microscopic confirmation of malaria parasites. In many regions, treatment requires a positive test result, exacerbating the issue.
The study found 80% of parasites in affected areas lack the PfHRP2 and PfHRP3 proteins that standard rapid tests detect. While their exact role remains unclear, widespread testing appears to have selected for these marker-less strains.
High-risk areas have shifted to alternative tests targeting other proteins, but these are less accurate, heat-sensitive, and harder to deploy at scale. Microscopic examination, though reliable, demands costly equipment and skilled technicians, limiting its feasibility.